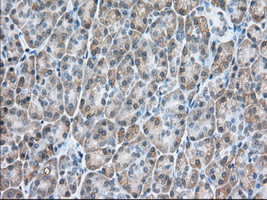
USP5 Antibody in Immunohistochemistry (Paraffin) (IHC (P))

Search
OriGene
USP5 Monoclonal Antibody (OTI2E3), TrueMAB™
{{$productOrderCtrl.translations['antibody.pdp.commerceCard.promotion.promotions']}}
{{$productOrderCtrl.translations['antibody.pdp.commerceCard.promotion.viewpromo']}}
{{$productOrderCtrl.translations['antibody.pdp.commerceCard.promotion.promocode']}}: {{promo.promoCode}} {{promo.promoTitle}} {{promo.promoDescription}}. {{$productOrderCtrl.translations['antibody.pdp.commerceCard.promotion.learnmore']}}
产品信息
TA501290
种属反应
宿主/亚型
分类
类型
克隆号
抗原
偶联物
形式
浓度
纯化类型
保存液
内含物
保存条件
运输条件
靶标信息
USP5 (ubiquitin carboxyl-terminal hydrolase 5) cleaves linear and branched multiubiquitin polymers with a marked preference for branched polymers. It is involved in unanchored Lys-48-linked polyubiquitin disassembly, and also binds linear and Lys-63 linked polyubiquitin with a lower affinity. Knock-down of USP5 causes the accumulation of p53/TP53 and an increase in p53/TP53 transcriptional activity because the unanchored polyubiquitin that accumulates is able to compete with ubiquitinated p53/TP53 but not with MDM2 for proteasomal recognition.
仅用于科研。不用于诊断过程。未经明确授权不得转售。
篇参考文献 (0)
生物信息学
蛋白别名: Deubiquitinating enzyme 5; Isopeptidase T; testicular tissue protein Li 218; Ubiquitin carboxyl-terminal hydrolase 5; ubiquitin isopeptidase T; ubiquitin specific peptidase 5 (isopeptidase T); ubiquitin specific protease 5 (isopeptidase T); Ubiquitin thioesterase 5; ubiquitin thiolesterase 5; ubiquitin-specific protease-5 (ubiquitin isopeptidase T); Ubiquitin-specific-processing protease 5
基因别名: ISOT; USP5
UniProt ID: (Human) P45974
Entrez Gene ID: (Dog) 486718, (Human) 8078, (Rat) 297593